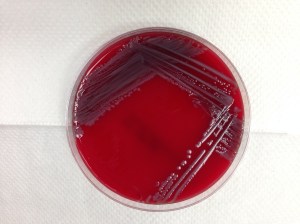
White-grey bacterial colonies growing on blood agar plate.

An 85 year old man presented with right medial upper thigh pain and swelling. Imaging revealed a large pseudoaneurysm in the right superficial femoral artery with evidence of rupture. The patient was taken to the operating room for placement of a gortex stent graft. His postoperative course was complicated by development of a large hematoma at the surgical site. Incision and drainage of the hematoma was surgically performed and fluid from the hematoma was sent to the microbiology laboratory.

Laboratory Identification:
The gram stain and plates confirmed the bacteria were non-lactose fermenting, non-hemolytic gram negative bacilli which is consistent Salmonella. Salmonella species was confirmed by mass spectrometry. Another feature helpful in the identification of Salmonella is its ability to produce hydrogen sulfide. Although not performed in this case, Salmonella will produce colonies with black centers when grown on Xylose lysine deoxycholate agar (selective agar that has thiosulfate which Salmonella metabolize to hydrogen sulfide).
The bacterial isolates of Salmonella were forwarded to the public health laboratories where serotype is determined based on serologic reactions to O and H antigens. The O antigen is the most external component of the lipopolysacccharide of gram negative bacteria and the H antigen is the antigenic determinant that makes up the flagellar subunits . This Salmonella species was identified to be S. enteritidis. Two sets of the patient’s blood cultures also grew S. enteritidis.
Discussion:
Salmonella are motile, gram negative bacilli that are widely disseminated in nature. Various animals such as turtles, lizards, snakes and birds are associated with Salmonella. Salmonella may infect humans via ingestion of contaminated food products that are typically of poultry or dairy origin. Person to person transmission may also occur by fecal-oral route. Salmonella has multiple virulence factors that allow it to evade the immune system. One of its virulence factors is the polysaccharide capsule that surrounds the O antigen. The O antigen is highly immunogenic and shielding the O antigen prevents its recognition by antibodies. Additionally, Salmonella can periodically change its H antigen as another protective mechanism against antibodies.
Jill Miller, MD is a 2nd year anatomic and clinical pathology resident at the University of Vermont Medical Center.
–Christi Wojewoda, MD, is certified by the American Board of Pathology in AP/CP and Medical Microbiology. She is currently the Director of Clinical Microbiology at the University of Vermont Medical Center and an Assistant Professor at the University of Vermont.

Reblogged this on BIOLOGY ELITES BLOG.
So, how can Salmonella infect the soft tissue or incorporated in the hematoma in this case?
Up to 8% of patients with nontyphoidal Salmonella gastroenteritis develop bacteremia, which our patient had. Of the patients that develop bacteremia, 5-10% will develop localized infections. This patient’s vascular graft put him at higher risk for endovascular infection. The organisms cross the epitheliam barrier in the GI tract, enter macrophages, and that is how they get into the blood stream.